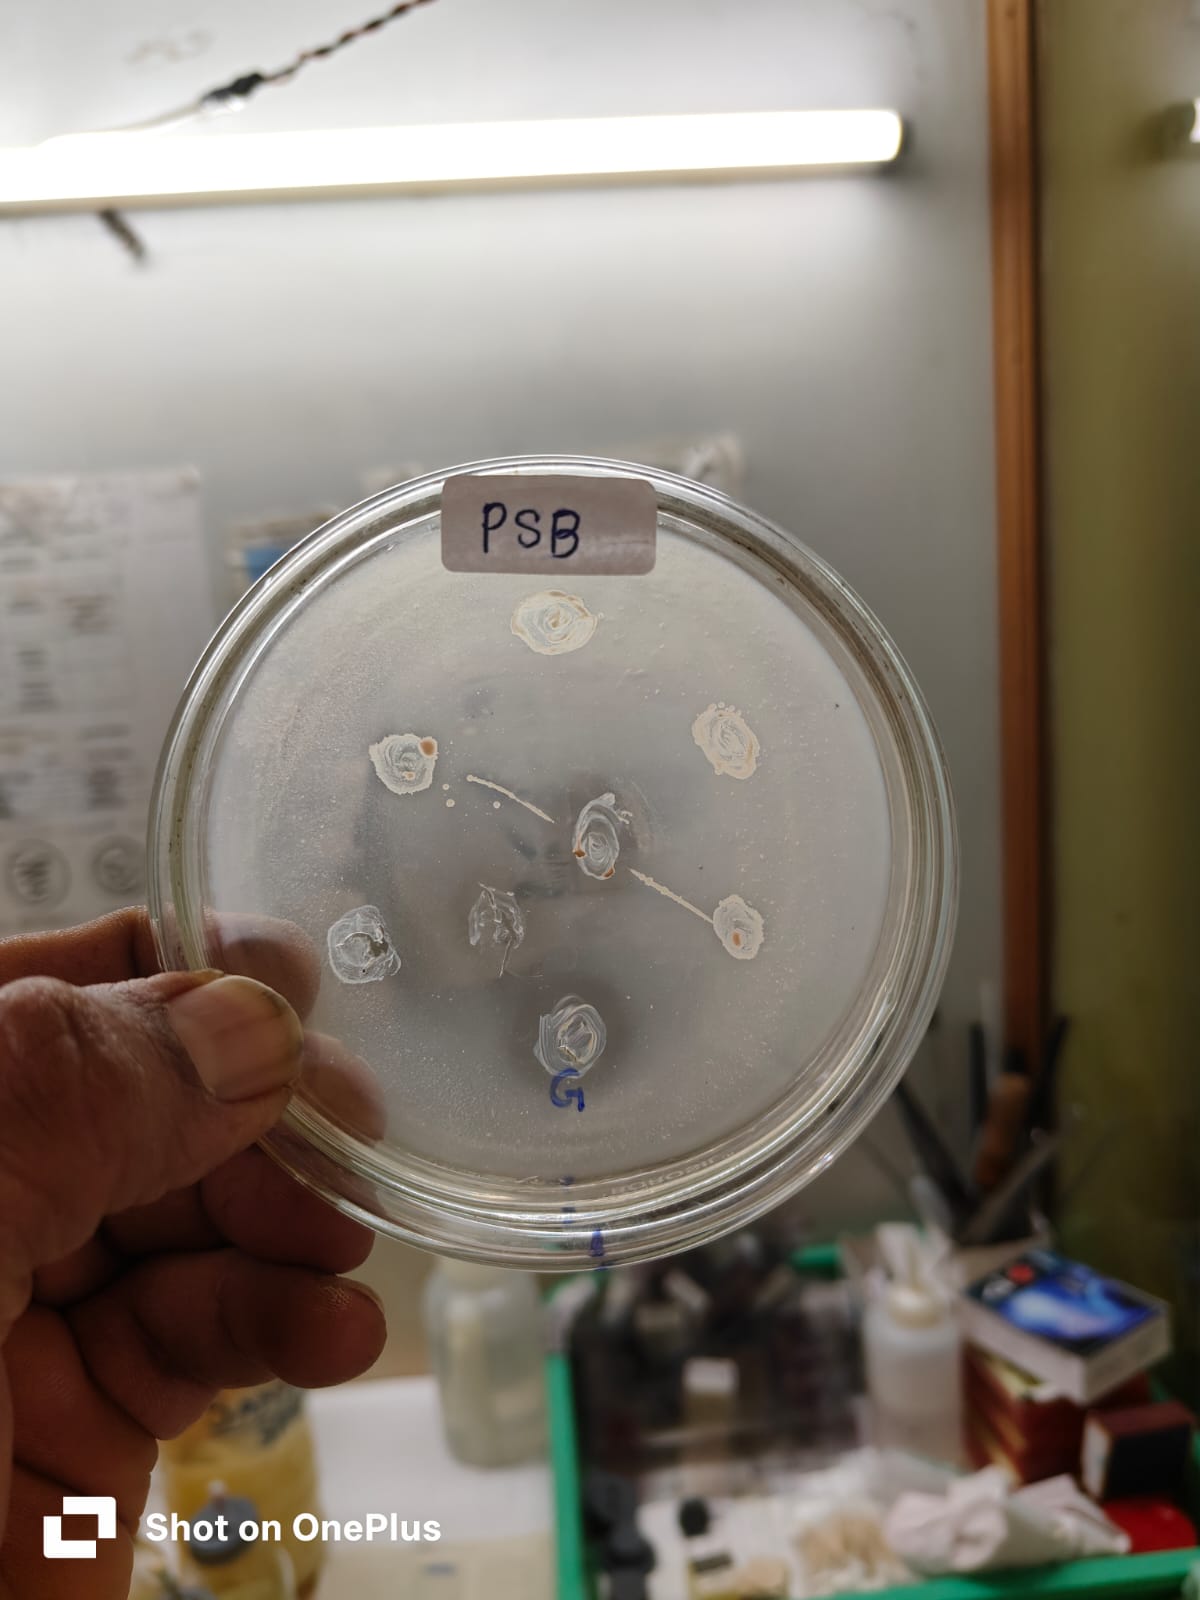
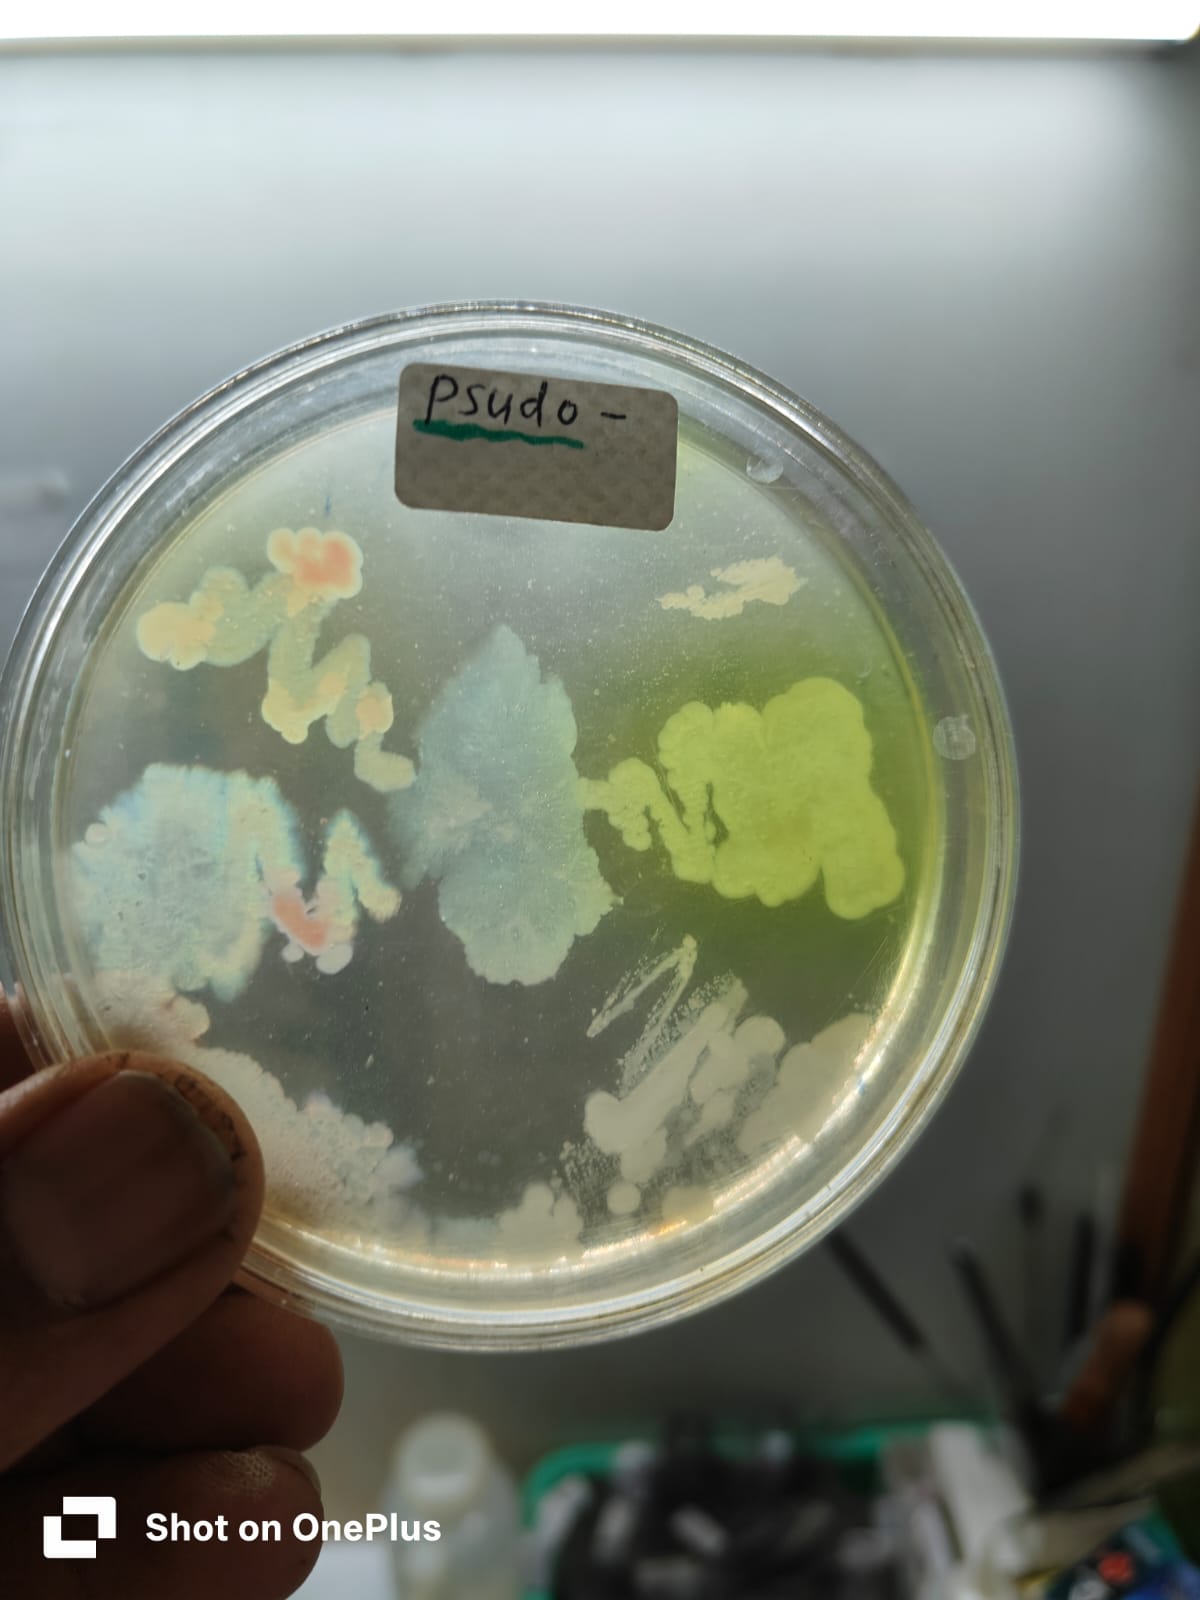

Cultivating Life at Every Scale






My Self Dr. Sanjay R. Gulhane (M.Sc. Ph.D in Microbiology from Sant Gadge Baba Amravati University. I did my P.G. in Microbiology and from that period I wanted to deserve my knowledge for farmers & society.For production of “Bio-Fertilizer” I had taken & completed my training in IARI Pusa New, Delhi. Today on Bio-control in Allahabad Agriculture Deemed University, Allahabad (U.P.).

All our Bio-fertilizers and Bio-cultures are developed and tested in a well-equipped laboratory, ensuring consistent quality and proven positive results.
We focus on pure, effective microbial strains that improve soil fertility, enhance plant growth, and protect crops from harmful diseases.
We don’t just sell products—we understand farmers’ problems and provide practical solutions so that works in real field conditions.
Our products support organic and sustainable farming, reducing dependency on chemical fertilizers and protecting soil health.
Every batch undergoes quality checks to maintain effectiveness, safety, and reliability….





Samruddhi Agro Lab is dedicated to improving soil health, crop productivity, and sustainable agriculture through advanced soil testing, bio-fertilizers, and scientific solutions.
🌱 Bio-Fertilizer Production
🦠 Trichoderma Culture
🌾 Crop Nutrition Guidance
📈 Farmer Consultancy
Address : Samruddhi Microbiology lab, Sangram Nagar, near Gayatri Nursery, Badnera Road, Amravati. Maharashtra, India
Phone : 9422190149
Email : meshrammanav264@gmail.com
Phone : 7385075328